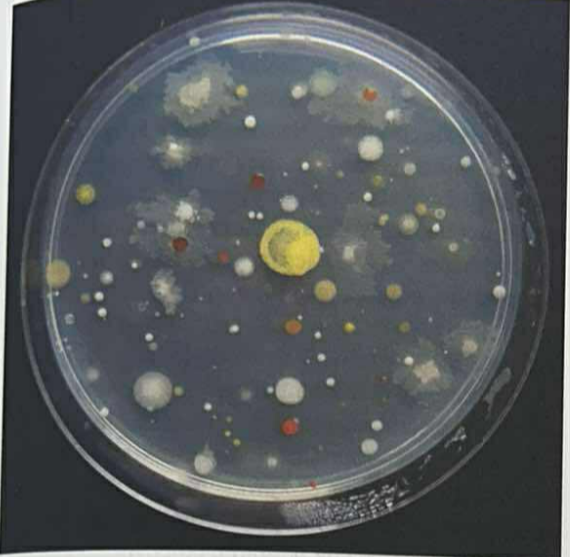
<p><span>💧📏</span> <strong>Małą objętość (ok. 0,1 ml)</strong>.</p><p><br></p><p><span data-name="round_pushpin" data-type="emoji">📍</span><span data-name="broom" data-type="emoji">🧹</span><span><span> </span></span>Materiał nanosi się pipetą na powierzchnię pożywki stałej, a następnie rozprowadza wyjałowioną głaszczką.</p><p></p><p></p><p><span data-name="petri_dish" data-type="emoji">🧫</span><span data-name="sweat_drops" data-type="emoji">💦</span><span> </span>Przy ocenie liczebności próbę powtarza się kilka razy dla różnych rozcieńczeń.</p>
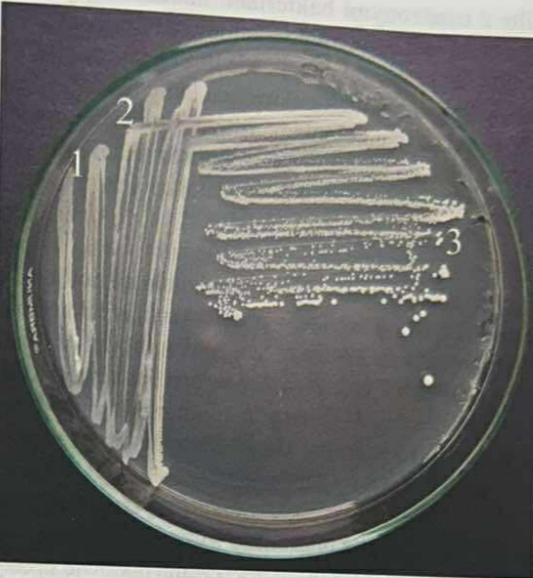
<p><span>📉🔢</span> <strong>Posiew redukcyjny</strong> (metoda suchych rozcieńczeń).</p><p><br></p><p><span data-name="book" data-type="emoji">📖</span><span data-name="speech_balloon" data-type="emoji">💬</span><span><span> </span></span>Polega on na rozprowadzaniu materiału ezą w kolejnych sektorach płytki, wypalając ezę między sektorami, co pozwala uzyskać <strong>pojedyncze kolonie</strong> (czyste kultury).</p>

1/37
Show must go on...
Name | Mastery | Learn | Test | Matching | Spaced |
|---|
No study sessions yet.
🧫🌱 Podłoże z namnożonymi na nim mikroorganizmami.
📖💬 Mogą być płynne lub stałe (zależnie od konsystencji podłoża).
❓🔬 Czym jest hodowla mikrobiologiczna?
☁ Wzrost dyfuzyjny (równomierne zmętnienie, np. E. coli),
🍞 Kożuszek/błonka na powierzchni (np. Bacillus, Azotobacter),
⬇ Osad na dnie (np. paciorkowce, pakietowce).
❓🧪 Jakie trzy podstawowe typy wzrostu można zaobserwować w hodowlach płynnych?
🚥🌀 Różne typy wzrostu mogą występować w połączeniach (np. zmętnienie i osad).
🚥❗ Typ wzrostu zależy również od:
➕🧪 właściwości podłoża (np. kożuch nie pojawia się w obecności związków zmniejszających napięcie powierzchniowe);
❓⚗ sposobu prowadzenia inkubacji (np. kożuch i osad nie pojawią się w hodowli wytrząsanej).
❔🚥 Opisz zależności dotyczące powstawania różnych rodzajów wzrostów [3].
🧬🔍 Czysta kultura.
📖💬Mikroorganizmy w niej stanowią potomstwo jednej, pierwotnie wyizolowanej komórki.
❓🧫 Jak nazywamy hodowlę, w której rośnie tylko jeden gatunek mikroorganizmu wywodzący się od pojedynczej komórki?
🏷🦠 Szczepami.
📖💬 Są to mikroorganizmy tego samego gatunku, wyprowadzone z różnych czystych kultur, izolowanych niezależnie od siebie (mogą różnić się cechami, np. zjadliwością).
❓📑 Jak nazywamy kultury tego samego gatunku, ale pochodzące z niezależnych izolacji?
👁🟣 Kolonia.
🧮💬 Średniej wielkości kolonia zawiera około 109 (miliard) komórek bakteryjnych.
❓👀 Jak nazywa się widoczne gołym okiem skupisko drobnoustrojów na podłożu stałym i ile mniej więcej zawiera komórek?
🌱🟩 Murawa (ang. bacterial lawn).
📖💬Występuje, gdy na płytkę wysiejemy bardzo dużo komórek i nie tworzą one oddzielnych kolonii, lecz rosną gęsto obok siebie.
❓🌿 Jaki typ wzrostu na podłożu stałym powstaje przy bardzo gęstym posiewie?
🌡🎨 Od rodzaju podłoża oraz sposobu inkubacji.
📖💬Przykład: Serratia marcescens wytwarza czerwony barwnik (prodigiozynę) tylko w temp. <30°C i w obecności tlenu.
❓🌈 Od jakich czynników zależy morfologia kolonii (wygląd, kolor)? Podaj przykład.
🥄🧪 Metalowe ezy, szklane pipety, głaszczki (szklane lub metalowe).
📖💬 Służą one do zaszczepiania podłoży płynnych i stałych oraz rozprowadzania zawiesiny.
❓🛠 Jakie podstawowe przyrządy laboratoryjne wykorzystuje się do posiewu mikroorganizmów?
Skup się na podłożach stałych oraz płynnych.
💧📏 Małą objętość (ok. 0,1 ml).
📍🧹 Materiał nanosi się pipetą na powierzchnię pożywki stałej, a następnie rozprowadza wyjałowioną głaszczką.
🧫💦 Przy ocenie liczebności próbę powtarza się kilka razy dla różnych rozcieńczeń.
❓🔬 Jaką objętość zawiesiny nanosi się zazwyczaj w metodzie posiewu powierzchniowego (na płytki Petriego ~9 cm)?
Określ też w jaki sposób ocenia się tą metodą liczebność mikroorganizmów.
📉🔢 Posiew redukcyjny (metoda suchych rozcieńczeń).
📖💬 Polega on na rozprowadzaniu materiału ezą w kolejnych sektorach płytki, wypalając ezę między sektorami, co pozwala uzyskać pojedyncze kolonie (czyste kultury).
❓🔥 Jak nazywa się metoda posiewu wykonywana ezą, służąca do uzyskania pojedynczych kolonii poprzez stopniowe rozcieńczanie materiału na płytce?
💉🐛 Igły mikrobiologicznej.
📖💬 Słupek z podłożem półpłynnym szczepi się wbijając igłę w głąb. Metoda ta pozwala sprawdzić zdolność bakterii do ruchu.
❓🏃 Jakiego narzędzia używa się do posiewu słupkowego (kłutego) w podłożu półpłynnym i jaką cechę bakterii on bada?
🧂⚠ Roztwór fizjologiczny (0,85% NaCl) – nie zawsze odpowiedni (brak buforowania, możliwy szok dla komórek).
👍 Zbuforowany roztwór fosforanowy (z dodatkiem peptonu/żelatyny) – lepszy, chroni komórki.
❓🧪 Czego używa się do rozcieńczania zawiesiny bakteryjnej i który roztwór jest bezpieczniejszy dla drobnoustrojów?
🥛🌡 Posiew wgłębny (metoda płytek lanych / pour plate).
⚙📖 Do pustej szalki wlewa się 1 ml próbki, a następnie zalewa 20 ml upłynnionego agaru o temp. 45–50°C.
🦠🤿 Powstałe w ten sposób kolonie nazywa się koloniami wgłębnymi.
❓🍲 W jakiej metodzie posiewu kolonie rosną wewnątrz pożywki (wgłębnie) i jaką objętość próbki się w niej stosuje?
🚰🔍 Metoda filtrów membranowych.
📖💬Stosuje się ją, gdy liczba drobnoustrojów w próbce (np. w wodzie pitnej) jest bardzo mała. Przesącza się dużą objętość (np. 100 ml) przez filtr membranowy.
❓🚿 Jaka metoda posiewu jest idealna do badania wody, gdy spodziewamy się małej liczby bakterii w dużej objętości cieczy?
🍽🦠 Nakłada się go na płytkę z podłożem stałym.
📖💬Bakterie osadzone na filtrze pobierają składniki z pożywki pod spodem i wyrastają w postaci kolonii na powierzchni filtra.
❓📄 Co robi się z filtrem membranowym po przesączeniu przez niego badanej cieczy?
🌡📦 W cieplarkach (inkubatorach).
📖💬 Utrzymują one odpowiednią temperaturę wymaganą do wzrostu danych mikroorganizmów.
❓🔥 W jakich urządzeniach prowadzi się inkubację naczyń z hodowlami (probówek, kolbek, szalek Petriego)?
🔄🌪 Wytrząsarki.
📖💬 Są to specjalne cieplarki z platformą wykonującą ruchy koliste, co zapewnia ciągłe mieszanie i napowietrzanie hodowli.
❓🧪 Jakie urządzenie stosuje się do inkubacji płynnych hodowli bakterii tlenowych i jaki jest cel jego działania?
📉🌬 Zmniejszenie stężenia tlenu.
📖💬 Hoduje się je w specjalnych urządzeniach umożliwiających modyfikację składu atmosfery.
❓🔬 Jakiej modyfikacji atmosfery wymagają podczas inkubacji mikroorganizmy mikroaerofilne?
🚫💨 Całkowite usunięcie powietrza.
📖💬 Na jego miejsce wprowadza się gaz obojętny (np. azot).
❓☠ Jakie warunki należy stworzyć w urządzeniu do inkubacji beztlenowców?
💨🌫 Azot (N2).
❓🎈 Jaki jest przykładowy gaz obojętny wprowadzany do hodowli beztlenowców po usunięciu powietrza?
🏭🌿 Kapnofile.
📖💬 Wymagają one do wzrostu podwyższonego stężenia dwutlenku węgla (CO2).
❓😤 Jak nazywają się mikroorganizmy, które wymagają zwiększonego stężenia dwutlenku węgla w atmosferze hodowlanej?
🤖🔬 Metody bezpośrednie.
📖💬 Wykorzystują one mikromanipulator – urządzenie pozwalające pod mikroskopem pobrać pojedynczą komórkę za pomocą szklanej kapilary i przenieść ją do jałowego podłoża.
❓🧪 Jak nazywamy grupę metod izolacji, w której fizycznie pobiera się pojedynczą komórkę drobnoustroju i jakiego urządzenia to wymaga?
🧫✅ Że pojedyncze kolonie są czystymi kulturami.
📖💬 Zakłada się, że każda kolonia wyrasta z podziałów pojedynczej komórki (choć w praktyce bakterie mogą być „sklejone”).
❓🤔 Na jakim podstawowym założeniu bazują metody pośrednie izolowania czystych kultur?
📉🖌 Posiew redukcyjny,
🌧 Wysiew powierzchniowy,
🍲 Metoda płytek lanych (kolonie rosną wgłębnie),
📄 Metoda filtracji membranowej.
❓📝 Wymień cztery techniki posiewu stosowane w metodach pośrednich do uzyskania oddzielnych kolonii.
🕵♂️🔄 Wykonuje się posiew redukcyjny.
📖💬 Materiał pobiera się z wybranej kolonii i ponownie posiewa, aby sprawdzić jednorodność wzrostu.
❓🔬 Co należy zrobić po pobraniu materiału z pojedynczej kolonii, aby potwierdzić, że rzeczywiście jest ona czystą kulturą?
🧪📈 Hodowla wzbogacająca (ang. enrichment culture).
📖💬 Metodę tę wprowadził do badań mikrobiolog M. Beijerinck.
❓👨🔬 Jak nazywa się metoda stosowana, gdy poszukiwanego mikroorganizmu jest bardzo mało w próbce w porównaniu do innych drobnoustrojów?
🎯🚫 Płynne podłoże selekcyjne.
📖💬 Dobiera się skład podłoża i warunki inkubacji tak, aby pożądany gatunek mógł się namnażać, a rozwój innych był zahamowany.
❓🧫 Na jakie podłoże (stałe czy płynne) wysiewa się próbkę w metodzie hodowli wzbogacającej?
🔢💧 Metoda seryjnych rozcieńczeń (dziesięciokrotnych).
📖💬 Próbkę należy rozcieńczyć (np. 10−1,10−2 itd.) przed posiewem powierzchniowym, aby uzyskać policzalne, izolowane kolonie.
❓📉 Co należy zrobić z próbką zawierającą bardzo dużą liczbę mikroorganizmów przed zastosowaniem metody posiewu powierzchniowego?
🧫🔢 30 a 300 kolonii.
📖💬 Taka liczba jest uznawana za wiarygodną statystycznie do obliczeń (poniżej 30 błąd jest duży, powyżej 300 kolonie się zlewają).
❓📊 Jaka liczba kolonii na płytce jest uznawana za odpowiednią do obliczania liczebności drobnoustrojów (JTK)?
🧫🔢 jtk (jednostki tworzące kolonie)
📖💬 lub w języku angielskim cfu (ang. colony forming unit).
❓📏 W jakich jednostkach podaje się wynik liczebności mikroorganizmów w metodach pośrednich?
💧📉 Metoda seryjnych rozcieńczeń dziesięciokrotnych.
📖💬 Należy przygotować kolejne rozcieńczenia próbki, aby zmniejszyć liczbę bakterii do poziomu policzalnego na płytce.
❓🧪 Co należy zrobić przed posiewem, jeśli badany materiał zawiera bardzo dużą liczbę mikroorganizmów?
🔢✅ Od 30 do 300 kolonii.
📖💬 Poniżej 30 wynik jest obarczony dużym błędem statystycznym, a powyżej 300 kolonie się zlewają i są trudne do policzenia.
❓📊 Jaka liczba kolonii na płytce jest uznawana za wiarygodną do obliczeń w metodzie posiewu powierzchniowego?
x = a × b × 10
🧮📝Gdzie:
a – średnia liczba kolonii na płytce;
b – odwrotność rozcieńczenia (przelicznik);
10 – przelicznik objętości (bo wysiewa się 0,1 ml, a wynik podaje w 1 ml).
❓📐 Jaki wzór stosuje się do obliczenia liczby jtk w 1 ml zawiesiny przy wysiewie 0,1 ml próbki?
🍔🏥 W mikrobiologii żywności i medycznej.
📖💬 W tych dziedzinach kluczowe jest poznanie liczby bakterii żywych, zdolnych do namnażania i wywoływania zakażeń lub psucia żywności.
❓🏭 W jakich dziedzinach mikrobiologii szczególnie stosuje się metody pośrednie (hodowlane) i dlaczego?
🔬🆚🧫 Metoda bezpośrednia (mikroskopowa) daje zazwyczaj wyniki wyższe niż metoda pośrednia (hodowlana).
❓📈 Która metoda określania liczebności – bezpośrednia (liczenie pod mikroskopem) czy pośrednia (liczenie kolonii) – daje zazwyczaj wyższe wyniki?
❌🌍 Brak uniwersalnego podłoża (nie ma pożywki, na której urosną wszystkie mikroorganizmy).
💤 Bakterie niehodowalne (ang. non-culturable).
🍇 Skupiska komórek (kilka sklejonych komórek tworzy jedną kolonię, co zaniża wynik).
❓📉 Dlaczego liczba bakterii oznaczona metodą pośrednią jest niższa niż rzeczywista liczba komórek w próbce środowiskowej? (Podaj 3 powody)
🧟♂🌱 Tylko mikroorganizmy żywe.
📖💬 Muszą one być zdolne do wytworzenia kolonii na stosowanym podłożu w danych warunkach inkubacji.
❓🧬 Jakie mikroorganizmy są zliczane w metodach pośrednich?